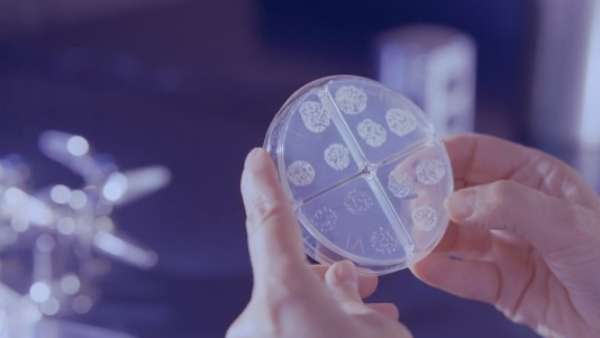

Открытое образование
Открытое образование
Готовимся к ЕГЭ по биологии! Молекулярная биология
- Сертификат: Нет
- Формат: Online
- Язык: Русский
- Осталось мест: не ограничено
Готовимся к ЕГЭ по биологии! Молекулярная биология
Программа рассказывает о том, как устроена клетка, каким образом она начинает функционировать, как хранится, воспроизводится и передается генетическая информация, а также о том, как клетки живут, размножаются и передают свою информацию следующим поколениям. Мы расскажем вам о принципах, участниках и этапах транскрипции, а также о том, какие существуют особенности регуляции транскрипции у эукариот и прокариот. Вы узнаете о фолдинге и синтезе белков в клетках. Научитесь читать геномы, а также узнаете о том, что такое мобильные генетические элементы. Вы узнаете о современных методах и направлениях исследований, диагностике и лечении наследственных заболеваний, генной инженерии и геномном редактировании.
Модуль 1. Основные понятия
- Вводное видео. О чем этот курс?
- Что изучает молекулярная биология?
- Биополимеры — основные молекулы клеток
- Структура и функции ДНК
- Структура и функции РНК
- Структура и функции белков
- Матричные синтезы
- Центральная догма молекулярной биологии
Модуль 2. Репликация
- Принципы репликации
- ДНК-полимеразы
- Молекулярная машина репликации
- Репликация в клетке
- Ошибки репликации и не только — мутации
- Системы репарации
- Репликация концов
Модуль 3. Транскрипция
- Понятие гена
- Принципы транскрипции
- РНК-полимераза
- Этапы транскрипции
- Регуляция транскрипции у прокариот
- Особенности транскрипции эукариот
- Регуляция транскрипции эукариот
Модуль 4. Трансляция
- Генетический код
- Рибосома
- Молекулы-переводчики
- Этапы трансляции
- Фолдинг белков
- Синтез белка в клетке
Модуль 5. Геномы
- Секвенирование — читаем геном
- Геномы вирусов
- Геномы прокариот
- Геномы эукариот и повторяющиеся последовательности
- Геномы митохондрий и пластид
- Мобильные генетические элементы
- Эпигенетическая регуляция работы генов
Модуль 6. Что нам дало знание молекулярной биологии?
- Полимеразная цепная реакция (ПЦР)
- Диагностика наследственных заболеваний
- Генная инженерия
- Клонирование
- Генная терапия
- Геномное редактирование
- Филогения и происхождение человека
 факультет
факультет 


